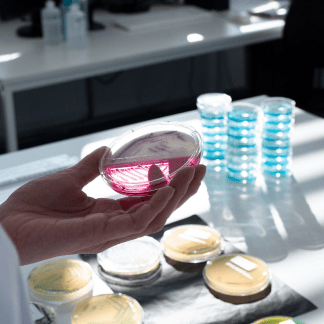

Laboratorio de Análisis Industriales
Análisis de Efluentes y Barros
Análisis de Aguas
Análisis de Emisiones Gaseosas
Análisis de Alimentos y Aditivos
Análisis de Ambiente Laboral
Análisis de Cosméticos y Medicamentos
La Empresa
Alimentaria San Martín SRL fundada en 1982, ofrece soluciones de análisis y control de calidad para la industria alimentaria, ambiental y bromatológica. Con más de 40 años de experiencia y certificación ISO 17025, garantizamos resultados confiables para asegurar la calidad y seguridad de tus productos. ¡Descubrí más sobre nuestros servicios!
Ver más
Desde 1995 integramos la Cámara de Laboratorios Independientes, Bromatológicos, Ambientales y Afines (CALIBA) lo que nos permitió lograr, conjuntamente con nuestros colegas, soluciones a la problemática específica de nuestro sector así como vislumbrar horizontes en común.
Esta trayectoria se tradujo en una vasta y sólida experiencia en microbiología y química para el análisis y la evaluación de alimentos, materias primas, agentes de limpieza, aguas, efluentes y contaminación ambiental.
Conscientes de que la base de este crecimiento ha sido la confiabilidad de nuestros resultados, hemos desarrollado e implementado un Sistema de Aseguramiento de la Calidad bajo los lineamientos de la Norma ISO 17025.
Todo lo expuesto nos ha valido los siguientes reconocimientos:
• Laboratorio acreditado OAA Laboratorio de ensayo N°LE 209. Consulte el alcance en www.oaa.org.ar
• Laboratorio bromatológico habilitado por el Ministerio de Salud de la Provincia de Buenos Aires,
Disposición Nro. 0480, Ley 11634, Dec. 1443/00.
• Laboratorio de análisis industriales habilitado Ministerio de ambiente de la Provincia de Buenos Aires (ex OPDS), Provincia de Buenos Aires, Nro. de Registro 038.
• Laboratorio de determinaciones ambientales habilitado NOLADA – CABA, Nº Reg. L019.
• Laboratorio perteneciente a la Red Federal de Laboratorios de Alimentos No. 02/3-71.

Nuestros Servicios de Análisis
Nos especializamos en el análisis de insumos industriales, brindando soluciones para evaluar la calidad y seguridad de productos como agentes de limpieza, desinfectantes, y materias primas.
A través de metodologías de última generación y normativas internacionales, garantizamos resultados confiables que cumplen con los más altos estándares de calidad y seguridad para tu industria.
Bromatología
PRODUCTOS TERMINADOS
Análisis de libre de gluten acreditado por norma IRAM 17025 y vÁlido ante INAL.
• Etiquetado nutricional para rótulo según normas del Código Alimentario Argentino / Mercosur (proteínas, hidratos de
carbono, grasas, humedad, fibra dietaría, cenizas, calorías, minerales).
• Análisis por HPLC: Edulcorantes no nutritivos, BHT, BHA, cafeína, vitamina C.
• Cromatografía gaseosa.
• Análisis por AA: espectrofotometría de absorción atómica modo llama; modo vapor frío y modo generación de
hidruros; modo Horno de Grafito: determinación de minerales y metales pesados.
• Viscosidad Brookfield y Saybolt.
• Filth test.
• Conservadores (benzoato, sorbato, sulfito, etc.).
• Alérgenos (restos de soja, gluten, sulfitos, etc.).
• Micotoxinas (DON, Zerealenona, Ocratoxina A, Aflatoxinas).
• Ensayo de vida útil.
• Recuentos, investigación de microorganismos según normativa oficial.
• Ensayos en enlatados (incubación, vacío, etc.).
• Campos positivos de mohos (Howard Stephenson).
Aditivos
• Concentración de principio activo.
• Contaminantes (metales pesados totales, plomo, cadmio, mercurio, arsénico).
Evaluación higiénico-sanitaria de procesos de elaboración de alimentos en fábricas, restaurantes, comedores de empresas y escuelas De acuerdo a los requerimientos de la norma FSSC 22000 para sistemas de gestión de seguridad alimentaria.

Medio Ambiente
AGUAS
• Potabilidad.
• Riego.
• Uso industrial.
• Subterráneas (Freatímetros y aguas profundas).
• Superficiales.
• Metodología analítica oficial: Standard Methods for the Water and Wastewater Examination, normas IRAM y OSN.
Efluentes
• Líquidos.
• Sólidos.
• Emisiones gaseosas.
• Extracción de muestras con certificado de cadena de custodia oficial del Ministerio de Ambiente, según Resolución
41/14 y emisión de los correspondientes certificados de informe.
• Extracción de muestras con certificado de cadena de custodia oficial Autoridad del Agua y emisión de los
correspondientes certificados de informe.
• Extracción de muestras con certificado de cadena de custodia oficial DPyRA según resolución 555/12 y emisión de
los correspondientes certificados de informe.
• Extracción de muestras compensadas de efluentes líquidos por medio de bombas de caudal variable, temporizadas
Metodología analítica oficial: Standard Methods for the Water and Wastewater Examination, normas OSN, IRAM, EPA,
NIOSH, OSHA, ASTM.
Consultoría en Medio Ambiente
Estudios de Impacto Ambiental

Seguridad e Higiene
AGUA
• Consumo humano (CAA, art. 982; Ley de Higiene y Seguridad en el Trabajo 19587, Autoridad del Agua).
Recreacionales (Ordenanza N° 41.718/87 del Boletín Municipal de la Ciudad de Buenos Aires; Decreto 3181/07 de la
Provincia de Buenos Aires)
Metodología analítica oficial
Standard Methods for the Water and Wastewater Examination, Normas OSN, IRAM, EPA, ASTM.
Contaminantes químicos en ambiente laboral según resolución 861/2015 SRT
• Material particulado total.
• Compuestos orgánicos volátiles.
• Humos de soldadura.
• Fibras de amianto.
• Metales pesados.
• Nieblas de aceite.
• Nieblas de ácido sulfúrico.
• Protocolo de ingreso a espacio confinado (CO; O2; H2S; explosividad).
Metodología analítica oficial
Normas IRAM, EPA, NIOSH, OSHA, ASTM.
Consultoría en Higiene y Seguridad Industrial

Otros
Análisis de Insumos industriales
• Agentes de limpieza y desinfección.
• Contenido de materia activa.
• Tensión superficial.
• Poder microbicida frente a microorganismos específicos.
• Punto de inflamación.
• Curva de destilación.
• Viscosidad Brookfield y Saybolt.
• Estudios de biodegradabilidad según IRAM 25610.
• Agentes de limpieza y desinfección.
• Contenido de materia activa.
• Tensión superficial.
• Poder microbicida frente a microorganismos específicos.
• Punto de inflamación.
• Curva de destilación.
• Viscosidad Brookfield y Saybolt.
• Estudios de biodegradabilidad según IRAM 25610.
Metodología analítica oficial: normas IRAM y ASTM, Farmacopeas.
PERITAJES OFICIALES
AUDITORÍAS Y ANÁLISIS DE PRODUCTO TERMINADO PARA EXPORTACIÓN.

Habilitaciones y Certificaciones
Nuestro compromiso con la calidad

Participamos regularmente de ensayos de aptitud interlaboratorio organizados por entes nacionales e internacionales
(CALIBA, COFILAB, INTI, Fapas)
Nuestro Sistema de Aseguramiento de la Calidad incluye la confidencialidad de los protocolos analíticos y su archivo (a disposición exclusiva del cliente) por un período de 8 años.
Igual importancia asignamos a la calidad de nuestra atención al cliente, basada en nuestro compromiso personal con su urgencia, necesidad de asesoramiento y, en suma, con la problemática que motiva su consulta.
Nuestros Clientes
Nos convertimos en socios estratégicos de nuestros clientes, trabajando codo a codo en sus procesos.
Por eso, estas son algunas de las empresas que confían en nuestros servicios.





















Formá parte de nuestro equipo
Si deseás acompañarnos en nuestra tarea, en Alimentaria San Martín le damos la bienvenida a quienes quieran desplegar
su carrera profesional siendo parte del equipo.
Todos los CV que se reciben son considerados con atención
y se analizan confidencialmente, para formar parte
de la base de datos de RRHH del Laboratorio.
Cada nueva búsqueda laboral se inicia recurriendo
a esta base de datos, que se actualiza permanentemente.